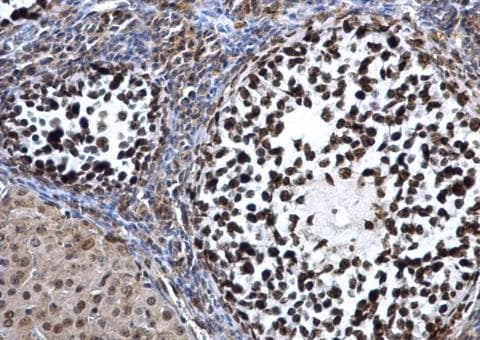
Anti-Dnmt3a antibody - N-terminal(AB228691)

Anti-Dnmt3a antibody - N-terminal(AB228691)
$undefined

| Shipped At Conditions | Blue Ice |
| Appropriate Long term Storage Conditions | Store at -20°C. |
| Clonality | Polyclonal |
| Applications | ICC/IF, IHC-P, IP, WB |
| Species Reactivity | Human, Mouse, Rat |
| Isotype | IgG |